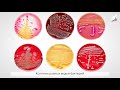

| Название | : | 5 класс биология урок 3 Царства живых организмов |
| Продолжительность | : | 13.32 |
| Дата публикации | : | |
| Просмотров | : | 4,3 rb |

|
|
Че так медленно идет Comment from : Drongus |
|
|
ЖОПЭО Comment from : Drongus |
|
|
ХЕЛОУ АНИМЕ ТОППППППППППП Comment from : stronger_So2 |
|
|
Спасибо Comment from : DRAGON 🐲 |
|
|
-" спс Comment from : Yuna Hanahaki🍡 |
 |
Биология 7 класс (Урок№1 - Классификация живых организмов. Бактерии.) РѕС‚ : LiameloN School Download Full Episodes | The Most Watched videos of all time |
 |
Разнообразие живой природы. Царства живых организмов. Отличительные признаки живого. Видеоурок РѕС‚ : InternetUrok.ru Download Full Episodes | The Most Watched videos of all time |
 |
6-класс | Биология | Многообразие живых организмов. Жизнь растений в природе РѕС‚ : Санарип Сабак - образовательные ресурсы Кыргызстан Download Full Episodes | The Most Watched videos of all time |
 |
Биология 9 класс. Многообразие форм живых организмов РѕС‚ : БИОЛОГИЯ Download Full Episodes | The Most Watched videos of all time |
 |
Биология 5 класс (Урок№13 - Характеристика царства Растения. Водоросли и лишайники.) РѕС‚ : LiameloN School Download Full Episodes | The Most Watched videos of all time |
 |
Биология 5 класс (Урок№10 - Классификация организмов.) РѕС‚ : LiameloN School Download Full Episodes | The Most Watched videos of all time |
 |
5 класс. Естествознание. Многообразие живых организмов. 21.04.2020. РѕС‚ : Онлайн-школа BilimLand Download Full Episodes | The Most Watched videos of all time |
 |
6 класс. Естествознание. Многообразие живых организмов. 21.04.2020. РѕС‚ : Онлайн-школа BilimLand Download Full Episodes | The Most Watched videos of all time |
 |
6 класс. Естествознание. Многообразие живых организмов. 17.04. 2020. РѕС‚ : Онлайн-школа BilimLand Download Full Episodes | The Most Watched videos of all time |
 |
Общая характеристика царств живых организмов. 7 класс. РѕС‚ : MEKTEП OnLine БИОЛОГИЯ Download Full Episodes | The Most Watched videos of all time |